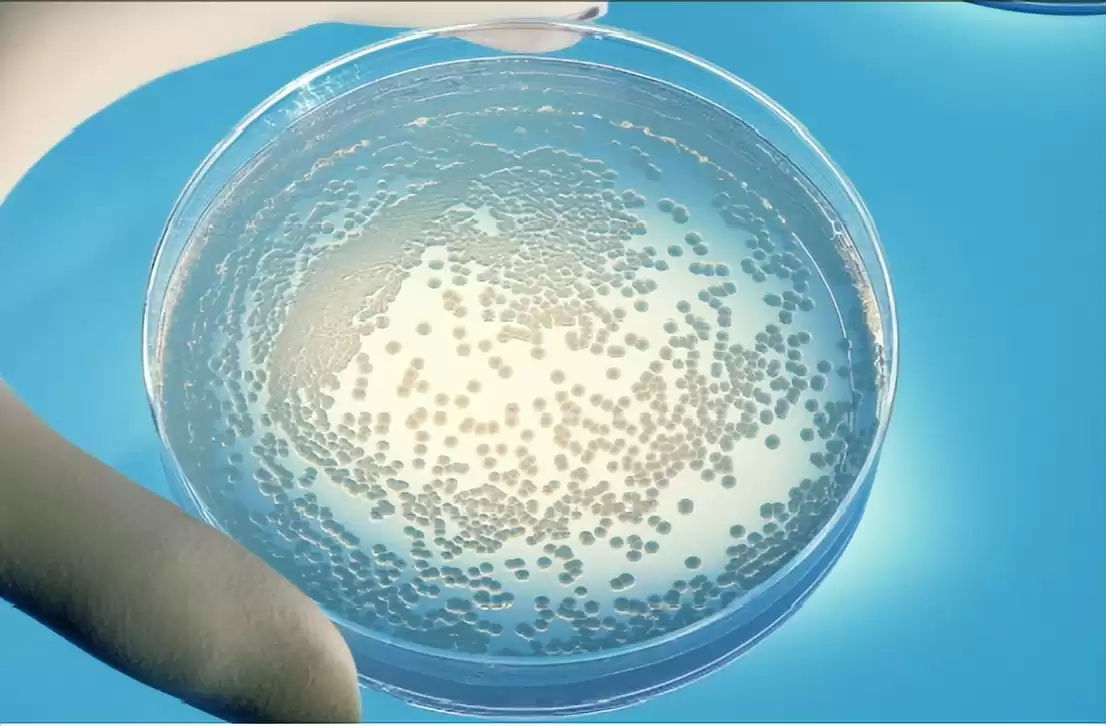
DNA克隆革命：科研成果大曝光，永生梦想近在咫尺？

克隆技术已取得哪些惊人突破?它真是永生的钥匙吗?
你是否好奇,克隆技术如何重塑科学边界?从多利羊到今日,它对我们究竟意味着什么?
七十年风雨兼程,克隆技术已跨越三大阶段,硕果累累!
简而言之,克隆技术通过无性生殖,创造出基因完全相同的生命复制品。
即使同卵双胞胎,基因也有细微差别,而克隆却能消除所有不同,实现完美复制。
早期,科学家在微生物克隆中摸索,技术生疏,投入巨大却收获甚微。
随着技术迭代,我们迈入遗传基因克隆新时代。
此时,DNA的“复制粘贴”已成现实,基因操控如臂使指。

基于前期积累,上世纪五六十年代,科学家成功克隆出“非洲爪蟾”,开启无性繁殖新纪元。
四十年磨一剑,1996年7月5日,克隆羊“多利”诞生,基因与原体完全一致,震惊世界。
如今,克隆技术日渐成熟,在农林牧业和医学两大领域造福人类。
在农林牧业,克隆技术助力良种培育,高效筛选抗病、高产的优质品种。
例如,科学家可克隆抗风林木,淘汰易病种类,提升生态效益。

更令人振奋的是,克隆技术为人类健康带来曙光。
在医学前沿,美、瑞等国正探索基因克隆在皮肤再生上的突破。
想象一下,大面积烧伤患者需植皮,但外体移植易排异,自体移植又受限。
外体移植引发排异,自体移植仅适用于小面积创伤,困境重重。
而克隆技术能制造“自体皮”,无限供应且零排异,改写医疗史。
无疑,克隆技术为延长寿命、提升健康开辟光明前景。
但为何克隆技术近年声量减弱?它真是永生的捷径吗?
三大桎梏阻碍其发展:技术不成熟、伦理冲击与法律缺失。
技术上,克隆羊多利五岁患关节炎,器官早衰,仅活六年。
这相当于人类三十五岁壮年,却疾病缠身,令人警醒。
六岁时,多利生命垂危,病因成谜,最终被安乐死。
二十一世纪初的突破,至今仅二十年,技术风险仍存。
谁能保证克隆人免于意外?技术不稳定,后果难测。
更甚者,克隆人无论存亡,均冲击人类伦理底线。
若克隆人健康成长,社会如何接纳?歧视尚存,人造生命更引争议。
克隆人作为人造物,必引发恐慌与伦理风暴。
各国严禁克隆实验,以维护社会稳态。

加之法律空白,一旦放开,克隆器官研究将失控。
进而滑向克隆人体,届时,克隆人是人是物?界限模糊。
尽管克隆技术有望通过器官克隆助人永生,但目前仍难实践。你认为人类该继续探索吗?分享你的观点,加入讨论!
相关问答
什么是基因克隆?
基因克隆指通过扩增技术(如PCR)将目的基因数量指数级增加的过程。
什么叫DNA克隆技术?
将外源DNA插入载体,转入微生物中扩增百万倍的技术。
DNA克隆概念
应用酶学方法,在体外将遗传物质与载体DNA结合成自我复制的DNA分子。
如何克隆一个基因?具体说明
首先获取目的基因(如从mRNA转录),再用PCR技术扩增并克隆。
克隆基因的方法?
通过酶学方法,将DNA与载体结合成复制子,进行克隆。
泰医什么是基因克隆,基因克隆包括哪些操作步骤
基因克隆是将外源DNA与载体结合,步骤包括获取基因、拼接与导入。
基因克隆技术有多种应用,包括重组蛋白的生产,遗传修饰生物体的构建,dna指纹
基因克隆技术用于生产重组蛋白、构建遗传修饰生物体及DNA指纹分析等。
基因克隆的几种常用方法?
常用方法包括从生物体提取目的基因、人工合成,以及与载体DNA拼接。
克隆技术与基因重组关系?
克隆技术涉及无性繁殖产生相同后代,基因重组则是在体外对DNA进行剪切和人工重组。
DNA能克隆出生命吗?
DNA克隆是细胞克隆的一部分,但克隆生命需复制整个细胞系统,不仅仅是DNA。